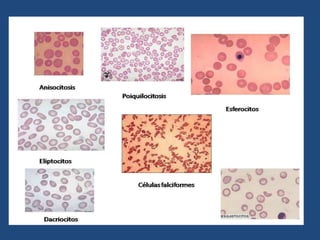

El documento resume la definición, clasificación, etiología, manifestaciones clínicas, diagnóstico y tratamiento de la anemia. La anemia se define como una disminución de la hemoglobina en la sangre que puede ser por pérdida de sangre, producción deficiente de eritrocitos o destrucción excesiva de los mismos. Existen varias clasificaciones de la anemia incluyendo la morfológica, funcional y según su etiología. El diagnóstico incluye exámenes de sangre para determinar los índ